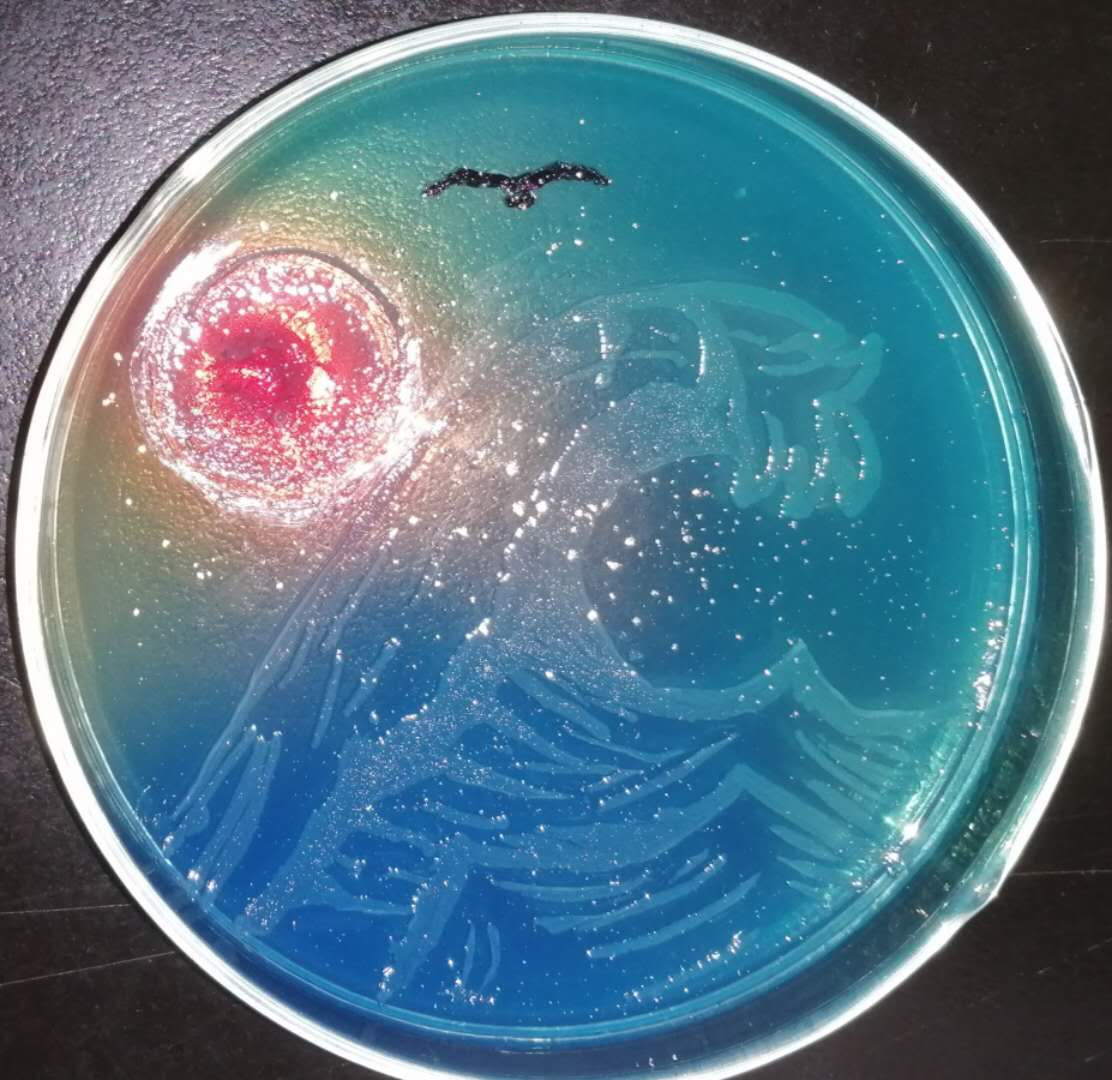

发布时间:2020-09-16 浏览量: 作者: 来源: 生物工程学院、教务处
生物工程学院微生物教研室:加强基层教学思政建设,坚持探索和实践新型教学模式
习近平总书记在北京大学师生座谈会上指出,高等教育是一个国家发展水平和发展潜力的重要标志,党和国家事业发展对科学知识和优秀人才的需要,比以往任何时候都更为迫切。党的十九大报告中也指出要“加快一流大学和一流学科建设,实现高等教育内涵式发展”。规模扩张并不意味着质量和效益增长,“内涵式发展”是大学教育发展的必然趋势。近年来,天津科技大学生物工程学院微生物教研室,在学校和学院两级领导的引导和支持下,努力加强基层教学思政建设,坚持育人为根本,坚持专业教育和思政教育紧密结合,并通过新型教学模式的探索实践,努力提高教学质量,助力我校培养思想茁壮、素质过硬的生物工程和制药工程人才。

微生物教研室的教学研讨活动
坚持育人为根本,专业教育和思政教育相结合
微生物教研室积极开展微生物相关课程的思政教学研讨,鼓励老师努力挖掘专业课程教学与思政教育的结合点和切入点,做到将两者有机融合。强调教师在专业课授课实践中,应当通过结合社会、经济和产业发展热点问题,努力激发学生的社会责任和担当意识。针对专业课教学中普遍存在的课堂感染力、实效性不强的问题,积极引导老师以开放的视野和创新的思路加强授课过程建设,努力让课堂真正“实”起来、“活”起来和“动”起来。
今年疫情期间,教研室就“如何在授课过程中结合新冠疫情热点问题进行思政教育”开展了积极的研讨和实践。新型冠状病毒肺炎疫情,是微生物学科领域在历史发展上的一个重要事件,对全球包括政治在内社会生活的各个方面都造成了深刻的影响。相关理论课或实验课中当涉及微生物传染与安全防护相关知识时,除了讲解新冠病毒的传染特点以及个人如何科学防护之外,重点向学生讲解党和政府实行群防群控、严格防疫措施的必要性和重要性,强调每个人都有责任去理解、遵守和配合防疫措施,并进一步通过国内外防疫对比让学生领会到我国社会制度在国家和人民危难之际所展现出的优越性。由于以科学、事实和学生自己的切身体会为基础,结合疫情防护进行的专业授课,让学生乐于其中的同时也收到了很好的思政教育效果。
该教研室全体教师积极参与教学改革并及时总结课程思政方面的经验,近三年来发表教改论文3篇,主持天津科技大学“十三五”教育教学改革1项、天津科技大学教育教学改革“课程思政”专项项目1项,教研室全体教师正在积极努力探索更具特色的课程思政方案。微生物教研室将进一步挖掘微生物相关专业教学所蕴含的思想和道德教育要素,通过与专业教学内容的融合,引导学生实现社会责任的内化和道德情操的提升。

微生物教研室疫情期间利用腾讯会议进行教学研讨
重视教学效果,积极探索和实践新的教学模式
微生物教研室日常坚持开展教学研讨活动,不断探索和实践新的教学模式,取得突出的教学成果。2018年“面向新工科建设生物制药创新人才培养的探索与实践”获得第八届高等教育天津市级教学成果一等奖。2019年,教研室改版了现有微生物学理论课和实验课教材,两本教材均获批中国轻工业“十三五”规划教材。2018年,结合天津科技大学学分制改革,教研室积极开展课程教学改革和实践,主干课程《微生物学》探索了“大班授课+小班辅导”的教学方式,加强教学过程管理,提高平时成绩所占比例,极大地提高了学生学习的积极性和自主性,经过三个学期的实践,教学效果显著。目前,《微生物学》课程已经成功获批天津市一流课程,正在积极参加国家级一流课程的评选。
微生物学是我校生物工程、制药工程、食品科学与工程、食品质量与安全、生物技术等专业最重要的核心基础课程之一,对该课程的掌握将直接关系到学生的培养质量和未来发展。该课程积极探索和实践的以“大班授课,小班辅导”为核心的混合教学模式,落实和强化了“以学生为中心的教学理念”。“大班授课”中教师为学生讲解教学大纲所规定的教学内容,“小班辅导”则主要进行案例分析、学生报告和随堂测验等,内涵丰富且注重过程性考核,并为学生提供个性化主动化的学习方案,努力将“老师被动教”转变成“学生主动学”,教改实践中大幅改善了教学效果。难能可贵的是,在受疫情影响只能网络授课的情况下,微生物教研室本着对学生和专业发展负责的精神,主动给自己加压加担,依然坚持了大班授课小班辅导的教学模式。
微生物学课程的建设经验和教学模式探索,为生物工程学院及我校其他课程教学模式改革提供了有价值的参考。

路福平教授微生物学课程网上授课和解答学生问题

微生物实验任课老师集体探讨教学方法
重视实践能力,以赛促学,强化特色,持续加强内涵建设
微生物教研室重视学生实践能力的培养,以赛促学,强化特色,持续加强内涵建设。不仅精心组织和打磨相关实验课程的教学,而且积极为学生搭建各种类各级别创新、创业和竞赛活动的参与平台,方便学生使用设备、场地和各种实验材料,保证学生能够获得专业老师的精心指导。
微生物实验课程是我校生物工程、制药工程、生物技术等专业重要的核心实践课程,教学质量直接关系到学生将来的工作和发展。在教研室的组织下,十几位任课老师日常坚持教学研讨,互相反馈和纠正,对实验动作进行标准化和统一化,让年轻教师快速成长。教研室还集体参与、精心制作了微生物实验课的课堂课件和演示视频等,并拓展了各种网络资源方便学生学习。由于平时的高标准要求,疫情期间微生物实验课的课件、视频和网络资源可以现成使用,老师们驾轻就熟,有力地保证了微生物实验课的教学效果。在学生返校后,老师们任劳任怨,在满足疫情防控的条件下,多批次安排线下实验补课,确保每位学生都能够掌握基本的实验技能,为学生继续学习专业课程奠定了基础。

微生物实验课老师向学生演示标准实验操作
在学生创新创业能力培养等方面,团队老师甘做学生的领路人,将自身科研成果与学生的兴趣和创新创业热情相结合,每年指导数十名学生参与“夜光杯”葡萄酒文化节、“海河杯”生物科技创新竞赛、“琼糯酩香”自酿米酒大赛、“挑战杯”、“大创”计划项目、“互联网+”大学生创新创业大赛等各种从校级到国家级的学生创新创业竞赛。
由微生物教研室承办的全校“微世界艺术大赛”,激发了学生对于微生物专业的热爱和对微生物世界的艺术情怀,受到学生们的热烈欢迎。例如2019年和2020年的“微世界艺术大赛”紧密结合我校60周年校庆、一带一路建设、抗击新冠肺炎疫情等主题,开展“课程思政教育+创新创业”相融合的特色实践活动,选送优异的微生物绘画作品参加全国培养皿艺术大赛。其中本教研室指导的参赛作品《飞天·敦煌》和《青花》分别荣获全国第三届和第四届微生物培养皿艺术大赛唯一金奖,展示了我校微生物课程在理论教学与实践教学相结合的、具有浓厚专业特色的创新创业活动中的实力与巨大潜力。


我校荣获2019年第三届微生物培养皿艺术大赛唯一金奖的作品《飞天·敦煌》(左)和指导老师王洪彬副教授(右)

我校荣获2020年第四届微生物培养皿艺术大赛唯一金奖的作品《青花》(左)及银奖获奖作品《忘川·落英缤纷》(中)、优秀奖获奖作品《炙浪》(右)





微世界艺术大赛的其他参赛作品
今后微生物教研室将继续秉承生物工程学院“厚基础、宽口径、强实践、重创新”的人才培养理念,不断尝试开展多样性的理论教学与实践教学改革,切实肩负起培养德智体美劳全面发展的社会主义事业合格建设者和可靠接班人的神圣使命。